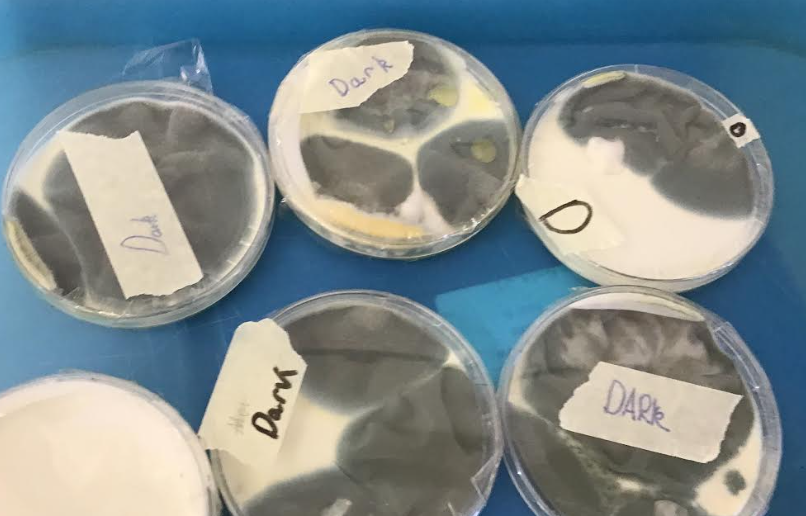

What are we Learning?
Friday 15th May
Well done Year 6 for your fantastic efforts in your SATs this week. You have worked so hard and we are all very proud of your resilience, determination and focus.
Friday 8th May 2026
We have had a lovely week in Year 6. A highlight of our week was in science, where we learnt about blood and what it is made up of: to embed our understanding, we recreated blood. We used water and yellow food dye to create the plasma. We then created the red blood cells using cheerios which we dyed with red food dye. To represent the white blood cells, we used mini marshmallows and to represent the platelets, we used raisins.



We learnt about the roles of the different parts of the blood and their importance. We drew and annotated models of our creations to further embed our understanding.
Skills 4 Life
In skills for life this week, we focused on the topic 'Aiming High'. In our first session, we considered what might influence people's decisions about a job or career. We learnt about some jobs being more highly paid than others and that people may also choose to do voluntary work that is unpaid. We looked at the sort of voluntary work that people might choose to do.
In our second lesson, we looked at identifying the kind of job that we might want to do when older and began to discuss and recognise the variety of routes into careers.
English
In English, we looked at opening a scene through a character description, drawing on using metaphors, personification and similes to add detail and create a vivid image for the reader.
Maths
In maths this week, we have been busy revising our arithmetic skills and applying them to word problems.
Friday 1st May 2026
Another lovely week in Year 6. In science, we have continued learning about the circulatory system: our focus this week was on the effect of exercise on the heart. We conducted an experiment to measure how our heart rate changed from a resting heart beat after 2 minutes of intensive exercise and the four minutes after that. We noticed that our heart rates rose rapidly during the exercise, then steadily declined again after exercising.
English
In English this week, inspired by our superb chocolate designs, we have written persuasive adverts, encouraging people to buy our wonderful chocolate bars!


We worked hard on opening with different openers and using persuasive techniques to entice our reader. We then rehearsed and presented our adverts to each other, ensuring to emphasise and draw on emotions using our language.


We are looking forward to editing and improving these next week.
Maths
In maths this week, we have focused on revising fractions: multiplying and dividing fractions, adding and subtracting fractions and calculating fractions of amounts.
Friday 24th April 2026
We have enjoyed our week in Year 6. In science, we have begun to learn about the circulatory system. As part of this, we recreated the circulatory system to show the movement of oxygenated and deoxygenated blood around the body and the role of the heart. We particularly liked the symbol of using a skipping rope to show the heart pumping. In PE, we have begun a unit on street art dance. We enjoyed using music to inspire us to create our own name tags through dance.

English
In English, we have been writing persuasively. We have looked at different ways of persuading and have identified the key features of persuasive adverts. We have created our own chocolate designs to include the wrapper, the look of the outside of the bar and a cross-section of the chocolate bar. We are excited to write persuasive adverts about our products.
Maths
In maths, we have been looking at sequencing as well as arithmetic skills and reasoning.
Friday 17th April 2026
What a great week of learning we have had in Year 6! In IT, we practised using micro:bits which was a challenge but fun. In PE, we have begun cricket and dance which has been great so far.
For our science lesson, we concluded our investigations as to the best conditions for growing mould. We drew results tables and line graphs to compare change over time.

English
In English this week, we have been practising setting the scene to a story by describing the setting. For the setting description, we focused on using the senses to add detail and prepositions to describe where things were. We then continued with dialogue to build tension. We did some drama to practise showing character through how we speak and actions to emphasise these. We loved acting and honing our skills with this.
Maths
In maths, we have begun to look at algebra in more depth, making expressions and equations with more than one unknown. We have been using bar models to help us with our understanding.
Thursday 26th March 2026
We have had another great week in Year 6. We have finalised our observations on our mould-growing investigation in science. It has been interesting to discover which environments provide the best conditions for growing mould.
We will be collating and looking at patterns in our observations after the Easter holidays.
Maths
In maths, we have finished our unit of work on coordinates across the four quadrants, reflection and translation. We have put these into practice through mystery investigations using these skills.
English
We have been working hard on finishing our non-chronological reports for our class book on Fantastic Beasts and Where to Find them. We have edited, improved and published these and are extremely proud of our work. Please read one of our superb pieces of writing below:



We wish everyone a lovely, restful Easter break.
Friday 20th March 2026
We have had a lovely week in year 6. We enjoyed having an opportunity to hold the ducklings! We also very much enjoyed the I-rock concert today.

Maths
In maths, we have focused on identifying coordinates in all four quadrants as well as finding missing coordinates.
English
In English, we have continued to write our non-chronological reports. They are absolutely fantastic so far, and we are excited to turn our final pieces into a class book.
Friday 13th March 2026
Science Week
We have had a fantastic week exploring different science. We had an excellent workshop where we investigated how high we could make fliers go. We came up with our own questions and changed different variables. We ensured that we only changed one variable and kept the rest the same so that it was a fair test.
The questions were varied: does the shape of the flier change the result, does how hard we hit the bottle change the height of the flier and does where we hit the bottle change the height of the flier? We then recorded our results and wrote our own conclusions in groups.

Continuing with our work on living things and their habitats, we are investigating the best conditions to grow mould. We have come up with our own variables to show what we are changing and what will be staying the same when measuring mould growth on yogurt. Some of us have chosen to compare warm and moist environments, some warm and dark, some dark and light, some cold and warm.
We will be observing and recording differences in mould growth over the next two weeks and presenting our findings in graphs.

We also had a fantastic workshop from Science Oxford which was very engaging, thought-provoking and inspiring. We really enjoyed this session.
In English, to link with the work that we did on Evolution and the influence of Charles Darwin, we have created our own creatures. We have made field sketches and annotations on them to show how they have adapted to their environments as well as their prey and habitats. We will be writing a non-chronological report about our creatures and creating a class book of Fantastic Beasts and Where to Find Them, inspired by our work on Harry Potter and the Philosopher's Stone this term.




Friday 6th March 2026
World Book Day




Friday 27th February 2026
What a fantastic first week back! On Tuesday, we had an art and music day which was excellent. We focused on 'Mambo' by Leonard Bernstein.
We discussed movement in art and created our own drawings based on the movement we felt was created in the music. We then looked at Cecilia Rivera's artistic interpretation of 'Mambo' and created our own versions.


Using stop-motion, we then watched Barry Purves animator clip on 'Mambo' and created our own animations. We had a lot of fun doing these. We spent time discussing the abstract ideas that Barry Purves used and the themes and rhythms within the animation.

After lunch, we joined year 5 to create a weak and strong alternating pulse with the class using body percussion. We then split into groups of mixed year 5 and 6 and used instruments to create our own weak/strong rhythms. We ended the day with each group performing to everyone.

Friday 13th February 2026
Mental Health Week
This week, we have done daily lessons linked to this, focusing on a variety of learning objectives:
- being able to explain our understanding of concepts relating to mental health and well-being by explaining why mental health is important, how to promote it, how to overcome negative emotions and develop self-awareness
- recognising the ways in which we are all unique by identifying strengths, qualities, likes and interests
- considering the ways in which our personal identity can help us to connect with others to feel a sense of belonging
- recognising how to feel connected with others and feel a sense of belonging
- learning to increase our personal sense of belonging and connection
We did this through a range of discussions and practical activities and artwork.

DT
In DT, we have continued with creating sculptures. We created wire figures, and then we sculpted them - the children thoroughly enjoyed doing this.

Friday 30th January 2026
This week we have been busy with lots of learning! In history, we spent some more time looking at Stoke Mandeville and its changes over time: this included looking at buildings in the village which are listed and have been here for many years. We looked at evidence of industry going back 150 years, and we looked at the census to see how the population has grown. In Science, we researched the work and life of Carl Linaes and presented our findings in a fact file.
English
In English this week, we have been busy designing wands and writing persuasive adverts to persuade a witch or wizard to buy one. We have looked closely at the skills needed to make our adverts persuasive. We really enjoyed doing this.
Maths
In maths, we have begun to look more closely at decimals and how we can convert between decimals and fractions.
Friday 23rd January 2026
Over the last 2 weeks in science, we have been busy looking at how animals and plants are classified – we have researched and created our own branching databases. In history, we have been continuing to learn about Stoke Mandeville. We have learnt about primary and secondary sources, and we have focused on the discovery of the old St Mary's Church during the HS2 works. We looked at the site that was created for archaeologists to research, discussed artefacts that were discovered and considered the timeline with regard to key historic dates that were confirmed through these finds.
In art, we have begun to look at sculpture and created our own foil figures:

English
In English, we have been writing our own creative stories where Harry accidently does magic. This has been inspired by the Vanishing Glass chapter of Harry Potter. The class have loved writing these and have come up with some fantastic ideas and settings for how this happens.
Maths
In maths, we have begun to look at decimals in more depth. We have looked at decimals to three digit places and multiplying and dividing decimals by 10, 100 and 1000.
Friday 9th January 2026
We have had a good first week back in Year 6. We have started our new topics which we are very excited about. In Science, we have begun to look at living things and their habitats. In history, we will be doing a local history study of Stoke Mandeville and in art, we will be looking at sculpture. In PE, we will be doing dance and basketball.
English
This term, we will be reading the first Harry Potter. We have designed our own wizards this week and have written a character description on them, which we loved doing.
Maths
In maths, we have focused on completing our fractions unit – our focus has been on dividing fractions and finding fractions of amounts.
Friday 19th December 2025
We have had a great, fun-filled last week of term. We enjoyed finishing our science topic on Evolution and Inheritance by building our understanding of how humans have evolved over time. We had an excellent afternoon doing a Christmas quiz with Year 5, a fantastic trip to the pantomime to see Jack and the Beanstalk, and we very much enjoyed weaving our own Christmas bauble decorations. In ICT we have been working on building our skills using Tinkercad and these are the 3D name badges that we created:


Friday 12th December 2025
What a great week we have had in Year 6! On Monday, we very much enjoyed going to the church to create our Christingles and participated brilliantly in the Christingle service on Tuesday.


In BSL this week, we practised our signing to direct our figurines across the maps that we created.


We have been enjoying our 'Evolution and Inheritance' topic in Science. This week, we looked at how fossils help us to learn about organisms. We researched an extinct animal and looked at how sometimes these are descendants from living animals. We have completed our DT topic and are very proud of our finished products.



In Geography, we used Digimaps to compare and contrast land use in St Petersburg, Russia to Aylesbury and our local area.
English and Maths
In English, we have finished our recount letters inspired by the 'Christmas Truce' and in maths, we have focused on converting mixed numbers and improper fractions as well as adding and subtracting mixed numbers. We have applied this understanding to reasoning and problem-solving questions.
Friday 5th December 2025
In year 6 this week, we have had an interesting week of learning. We are looking forward to sharing some photos from our 'make-do and mend' Christmas stocking creations' project next week. We have very much enjoyed doing this.
In science, we focused on how plants adapt to their environment and looked at differences between plant features in different biomes. We then created our own ideal plant for our chosen environment which would have the best chance of survival. In Geography this week, we looked at different climates across Europe – in particular, focusing on Eastern Europe. We researched the different weather patterns that are likely to be found in these climates and then identified examples of European countries within each climate.
English
In English, we have been focusing on the 'Christmas Truce'. We have watched the advert created to show this and have been writing a letter recounting the events. The class enjoyed considering the different emotions that this would have brought up and empathising with the situation.
Maths
In maths this week, we have continued our new topic on fractions. We have been looking at equivalence and converting between mixed and improper fractions.
Friday 28th November 2025
In year 6 this week, we have been very busy with our learning. In DT we are continuing with our 'make do and mend' Christmas stocking creations which we are looking forward to sharing. In science, we have been looking at how animals adapt to their environment. We have looked at the difference between natural selection and evolution as well as how characteristics are inherited. We researched different habitats and what the conditions were like in each environment. We then selected three animals from a chosen habitat to investigate what characteristics they had in order to adapt and survive in their environment. Finally, we discussed how animals may evolve in 10 million years' time, and we created our own evolved animals, taking into account what characteristics would make them the 'fittest' and best able to survive in their environment. These are some of the ideas we came up with:

English
In English this week, we finalised our Goodnight Mr Tom stories and edited and improved them. We have then published them,
Maths
After finalising our four operations unit, we have begun to look at fractions. We have begun by recapping what we know about fractions, identifying the denominator and numerator, drawing different fractions and adding and subtracting fractions with the same denominator,
Friday 21st November 2025
What a great week in year 6! We have been working hard in science to build our understanding of evolution and inheritance. We experimented with how different 'beak' types affect the ability to collect food sources and discussed how animals adapt to their environment and the fittest and strongest survive, which is how certain characteristics are inherited over time, leading to the evolution of species.




Maths
This week, we have completed our four operations unit. We focused on using BIDMAS to support our understanding of the order of operations: the order is Brackets, Indicies, Division and Multiplication and Addition and Subtraction.
English
In English this week, we have completed our adventure stories based on Goodnight Mr Tom. Zach and Willie went on an adventure, met difficulties along the way and these were resolved. We considered including a moral to the end of the story and focused on using the senses throughout to aid description and include a variety of feelings.
Friday 14th November 2025
This week we have had a focus on anti-bullying week. We have used discussion and role-play to help us to understand what bullying is and what strategies we can use to support if we feel bullying is happening. We have also been very excited to plan and prepare for the Children in Need fair on Friday afternoon. We also published our Remembrance poems and created a class Remembrance booklet of all of our poems.


English
In English this week, we have begun to plan a story for an adventure that Willie and Zach go on. We have looked at an opening, build up, problem, resolution and ending. We have focused on different types of beginnings including, speech, action, setting description and creating atmosphere. Using this, we wrote two different openers – one for describing the opening and another of our choice.
Maths
This week in maths, we have begun to look at long division. We have been practising the method and building or fluency skills.
Friday 7th November 2025
After a good half-term break, Year 6 have returned ready to learn and full of energy and ideas. We have had a great week. In Science, we have started our new topic on Evolution and Inheritance and have begun looking at inherited characteristics in living things and variation within offspring and across a species. In Geography, we have been looking at continents and Europe and identifying different countries, capitals and seas in and surrounding Europe. To consolidate our WW2 history topic, this term's focus will be reflecting 'Make do and mend' in creating stocking fillers – our first lesson on this has been designing our ideas. We are very excited about this project and in particular, practising our sewing skills!
English
We have particularly enjoyed our English lessons this week where we have focused on Remembrance Poetry. We have used the senses and a range of poetic devices to write some superb poetry both from the perspective of soldiers in the war and from a Remembrance day perspective. I am so proud of the poems that have been written and look forward to posting them next week once we have published them.
Maths
We have been working hard on the skill of short division this week. We have looked at dividing by 1 and 2- digit numbers and have been applying our understanding to word problems and reasoning questions.
Thursday 23rd October 2025
We have had a great week in Year 6. We consolidated what we learnt from our trip to SEALR and created posters about our learning. Here are some of our examples:



We have also completed our History topic on what it was like for children in WW2. We spent the lesson comparing entertainment today to in WW2. We discovered that the main difference was technology and that the toys would have been more often wooden and hand made as the resources were harder to source. We finished the lesson by playing a game of battleships which the children thoroughly enjoyed.
English
During our English lessons this week, we focused on how to present Chamberlain's speech announcing WW2. We listened to his radio podcast, then practised our own speeches, focusing on intonation, clarity, projection and pauses. We have also looked at how to expand sentences from a simple sentence to a compound sentence and then to complex sentences using different images for inspiration.
Maths
In Maths this week, we looked at square and cubed numbers, practising drawing them to build our understanding. We have then focused on multiplying by two digit numbers, drawing on our times table knowledge to help us.
Friday 17th October 2025
Another action filled week in Year 6! We have been focused on propaganda during WW2 and we have looked at the impact that this had on children as well as how this may have differed between the city and the countryside. We have created our own propaganda posters inspired by 'Dig for Victory', 'Mend and Make Do' and 'Keep Calm and Carry On'.

School Trip
This week, we were extremely fortunate to be invited to the SEALR site so that children could learn about changes in their local area. This was a fantastic opportunity and we felt very fortunate to have been invited. The children have been busy making posters about what they learnt which we will be sharing soon. They were able to walk and see the new road and roundabout, they used a simulator and VR headsets to see how to use and be safe around the machinery used on site, they were shown how the drones are used to support the road building and were able to ask a number of questions. It was very interesting to hear about careers opportunities and understand all of the different essential roles needed to build a road.



English
Using our Anderson Shelter models, we are creating instructions to explain how to make one. We are focusing on using subheadings, bullet points, ordering adverbials and a range of punctuation to write these. We are looking forward to sharing these once we have finished editing and improving them next week.
Maths
In maths this week, we have started looking at factors, multiples and prime numbers. We have ensured that we can identify them and understand what they are as well as beginning to explore reasoning and problem solving questions around them.
Friday 10th October 2025
Year 6 have been enthusiastic, determined and extremely hard-working this week. We had a fantastic art lesson completing our Blitz skylines with silhouettes. In science this week, we explored the relationship between light and shadows and looked at dependent, independent and controlled variables in order to experiment with how the shadow size changes as light is moved to greater distances from the object.

English
In English this week, we have been creating our own model Anderson shelters. This is linked to our WWII history topic but also to writing a set of instructions. We will be reflecting on the process of making Anderson shelters to plan and write these next week. We have loved making them and have worked fantastically in groups to do so.



Maths
In maths, we have continued practising our arithmetic skills and have focused on answering one and two- step word problems. We have continued to use the CUBES strategy to support our problem-solving. This involves circling key numbers, underlining the question, boxing important words, evaluating to decide on the operation and finally solving the problem.
Friday 3rd September 2025
We have had a great week of learning in Year 6 this week. We have really enjoyed working on making periscopes in science; we have explored how light travels and the angles that light reflects off mirrors at. We worked in teams to build these and evaluate what worked well and what needed to be improved to maximise how much could be seen. We have been really lucky to have an author visit this week, which the class thoroughly enjoyed. In art, we finalised our WWII aircraft and have begun to create a Blitz skyline using silhouettes.

Maths
In maths, we have started to consolidate our understanding of place value through applying it to addition and subtraction word problems. By underlining and circling key information, we are building our skills to be able to evaluate how to solve the problem and ensure that we are answering it with the correct unit of measure. The challenge has been to apply these to two-step problems.
English
In English and continuing with Goodnight Mr Tom, we have worked on describing a setting and describing a character. These have focused on Mr Tom's house and the newest character that we have been introduced to - Zach. We have been building our skills of using expanded noun phrases and prepositional phrases to do this. We are really proud of our final pieces of work.
Friday 26th September 2025
What an excellent week! Year 6 have been working hard and have been enjoying our World War II topic. We have learnt about rationing during WWII in our history lessons and in art this week we recreated WWII aircraft, focusing on shading to create a 3D image.
English
In our English this week, we have focused on empathising with our key character in the story 'Willie'. We wrote a letter to his mother about what it was like as an evacuee child in the countryside and how he was settling in with Mr Tom and Sammy the dog. The children then replied from the perspective of Mrs Beech to Willie's letter. I am really impressed with the way they have inferred from the text to empathise with these characters.
Maths
In maths this week, we have been focusing on negative numbers. We have looked at how we can apply this to 'real life' and have looked at adding and subtracting negative numbers. Towards the end of the week, we have started to look at multiplying by 10, 100 and 1000.
Friday 12th September 2025
What a fantastic start to the year! Year 6 have shown fantastic resilience and determination with sitting their 11+ this week and we are very proud of them for their efforts in this. They have approached our learning with an excellent attitude and have been trying their hardest in all curriculum areas. We could not have asked for more from them.
English
To link with our History topic on WWII and specifically 'What it was like for Children in WWII', we have started our class book Goodnight Mr Tom. The class very much enjoyed immersing themselves in the book and learning about the key characters, Mr Tom and Willie. We have used our knowledge from our history lessons about evacuees to write a first person account from the perspective of a child in WWII.


Maths
We have started our first maths unit on place value. Specifically, we have been looking at numbers to 10 million and we have been looking at estimating numbers on a number line when the end and start points vary and when the number of intervals changes.
Well done Year 6 for a fantastic start to the term.
